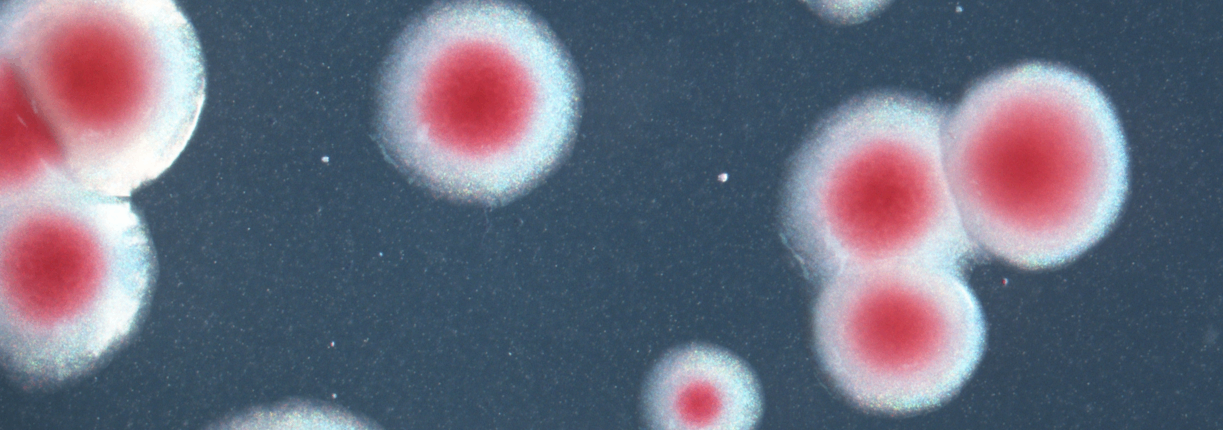

New edition: NMKL 117. Pathogenic Y. enterocolitica. Detection in food, animal feed and environmental samples.
The NMKL Method No. 117 “Pathogenic Yersinia enterocolitica. Detection in food, animal feed and environmental samples” 4th edition has been published. The principle of the 4th edition has been completely revised compared to the 3rd edition of the method (cold enrichment). Amended cold enrichment protocol has been included as ANNEX 3.
The method can be purchased for 60 Euro or downloaded free of charge for subscribers.